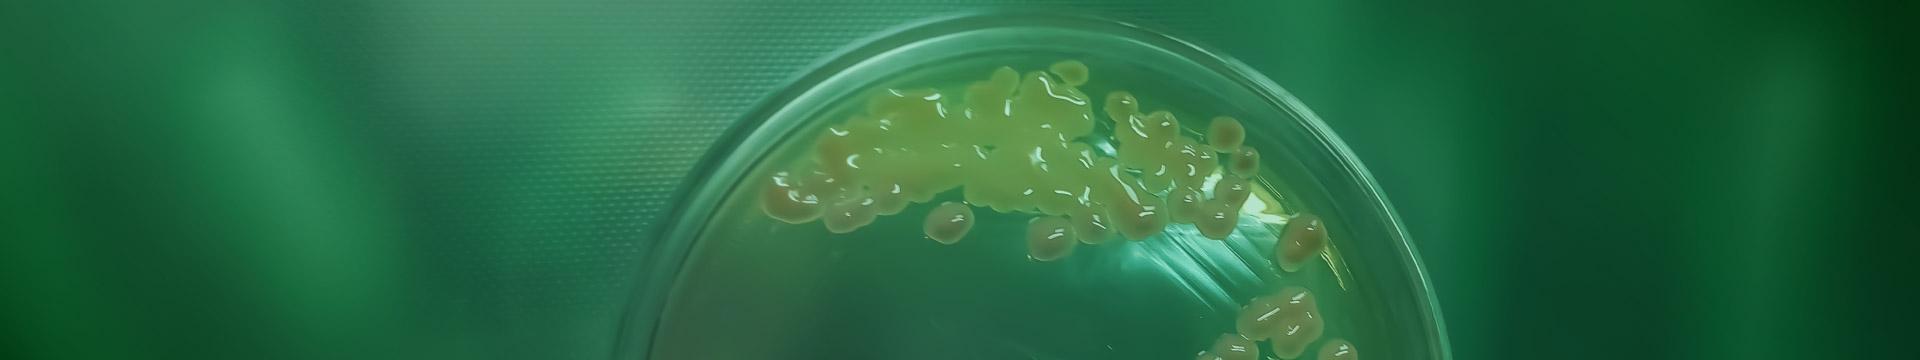

Bezpłatny webinar wprowadzający do szkolenia: „Badanie aktywności przeciwbakteryjnej związków w praktyce”
27 maja 2026 roku
19:00-20:00

Antybiotykooporność i biofilm należą do największych wyzwań współczesnej mikrobiologii, medycyny i biotechnologii. Podczas webinaru online omówione zostaną podstawowe metody badania wrażliwości drobnoustrojów na antybiotyki, z uwzględnieniem aktualnych wytycznych Europejskiego Komitet uds. Oznaczania Lekowrażliwości Drobnoustrojów (EUCAST) oraz Instytut Standardów Klinicznych i Laboratoryjnych (CLSI). Uczestnikom zostanie przybliżone, czym są te standardy, jak poruszać się po zawartych w nich zaleceniach oraz jak odczytywać i interpretować dane wykorzystywane w badaniach mikrobiologicznych.
W trakcie spotkania przedstawione zostanie także znaczenie biofilmu w zakażeniach oraz przyczyny, dla których jego obecność utrudnia skuteczną eliminację drobnoustrojów. Webinar będzie stanowił wprowadzenie do zagadnień związanych z oceną aktywności przeciwdrobnoustrojowej i skierowany jest do osób zainteresowanych nowoczesnymi metodami badawczymi w mikrobiologii.
Dr Joanna Budziaszek – mikrobiolożka i badaczka w obszarze biotechnologii medycznej, doktor nauk biologicznych, absolwentka Uniwersytetu Jagiellońskiego. Jej zainteresowania koncentrują się na badaniach zakażeń oraz ocenie skuteczności rozwiązań przeciwdrobnoustrojowych w kontekście zastosowań medycznych.
Specjalizuje się w mikrobiologii zakażeń oraz badaniach oddziaływań gospodarz–patogen, ze szczególnym uwzględnieniem mechanizmów wirulencji i unikania odpowiedzi wrodzonej. W swoich badaniach wykorzystuje liczne modele infekcji in vitro, ex vivo i in vivo – zarówno u kręgowców, jak i bezkręgowców.
Odbyła staż badawczy w Instytucie Biochemii i Biofizyki PAN (Laboratorium Bakteryjnej Oporności na Leki). Jest autorką i współautorką publikacji z obszaru mikrobiologii, immunologii i chorób zakaźnych oraz aktywnie prezentuje wyniki na konferencjach międzynarodowych (laureatka FEBS Fellowship na wyjazd na 48th FEBS Congress – Mediolan, 2024). Dr Budziaszek jest członkiem Polskiego Towarzystwa Biochemicznego oraz Polskiego Stowarzyszenia Biomateriałów.
W szkoleniach stawia na praktyczne podejście: dobre planowanie eksperymentu, krytyczną interpretację wyników oraz zasady pracy laboratoryjnej, które realnie zwiększają powtarzalność i wiarygodność danych – zarówno w badaniach akademickich, jak i w projektach R&D.
Obecnie związana z Siecią Badawczą Łukasiewicz – Krakowskim Instytutem Technologicznym, gdzie uczestniczy w realizacji projektów badawczych i rozwojowych na styku mikrobiologii i biomateriałów, postdoc w projekcie SONATA-19 NCN pod kierownictwem dr Barbary Pucelik.
Formularz rejestracji:
Rejestracja trwa do 26 maja 2026 roku.
Po wysłaniu formularza należy potwierdzić zapis klikając w link otrzymany w wiadomości e-mail (w przypadku nie otrzymania wiadomości prosimy o sprawdzenie folderów takich jak spam, oferty itp.). Jeżeli wiadomość nie dotarła w przeciągu 24h prosimy o kontakt pod adresem: sekretariat@fundacja-tygiel.pl
Regulamin
Regulamin webinaru dostępny jest tutaj -> LINK
Kontakt
sekretariat@fundacja-tygiel.pl






